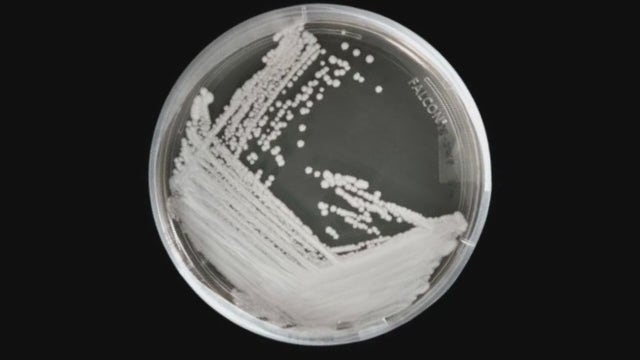
Fungal infection Candida auris on the rise, appears to be resistant to most drugs

Michigan organ donor registry sign-up option could be added to tax forms
Michigan residents could soon have another option to sign up to become organ donors. Lawmakers introduced a package of bills that would add the organ donor registry question to state income tax forms.
Michigan residents could soon have another option to sign up to become organ donors. Lawmakers introduced a package of bills that would add the organ donor registry question to state income tax forms.
Rabies patient becomes first fatal case in US after post-exposure treatment, report says
A Minnesota man is the first reported fatality due to rabies in the United States despite receiving appropriate post-exposure prophylaxis, according to a recent article published in Clinical Infectious Diseases.
A Minnesota man is the first reported fatality due to rabies in the United States despite receiving appropriate post-exposure prophylaxis, according to a recent article published in Clinical Infectious Diseases.
Tips for managing stress while helping family through a health crisis
Dr. Sabrina Jackson shares tips for helping you manage your stress levels when a family member needs care during a health crisis.
Dr. Sabrina Jackson shares tips for helping you manage your stress levels when a family member needs care during a health crisis.
Federal judge ruling makes it so insurers don't have to cover some preventive care services
This includes screenings for cancer, diabetes and mental health
This includes screenings for cancer, diabetes and mental health
‘God must have put you in my car!’: Uber driver donates kidney to passenger
A New Jersey man’s Uber ride turned into a trip that would save his life.
A New Jersey man’s Uber ride turned into a trip that would save his life.
CDC warns of Marburg virus after deadly Africa outbreak
The CDC is sending personnel to assist with the outbreak of the Marburg virus in Guinea and Tanzania.
The CDC is sending personnel to assist with the outbreak of the Marburg virus in Guinea and Tanzania.
Michigan Congressman Dan Kildee says he has cancer
Kildee represents the 8th Congressional District in Michigan. He plans to have the cancer removed in the next few weeks.
Kildee represents the 8th Congressional District in Michigan. He plans to have the cancer removed in the next few weeks.
Dentists reveal why you shouldn't brush your teeth in the shower
Dentists shared three risky reasons why brushing your teeth in the shower may be a bad idea.
Dentists shared three risky reasons why brushing your teeth in the shower may be a bad idea.
Nearly a third of leukemia patients saw remission after taking experimental pill
“As someone who does this for a living, this is incredibly gratifying," said one of the physicians overseeing the trial.
“As someone who does this for a living, this is incredibly gratifying," said one of the physicians overseeing the trial.
Metro Detroit cancer survivor shares story to raise awareness this National Colorectal Cancer Awareness Month
Rich Kynast didn't get his first colonoscopy until he was 54 and started having symptoms that worried him. Now, he hopes his story can teach others the importance of getting a colonoscopy.
Rich Kynast didn't get his first colonoscopy until he was 54 and started having symptoms that worried him. Now, he hopes his story can teach others the importance of getting a colonoscopy.
Infants exposed to pet dogs or cats may develop fewer food allergies, study finds
The study showed dog exposure was estimated to reduce the risk of egg, milk and nut allergies, while cat exposure was estimated to reduce the risk of egg, wheat and soybean allergies.
The study showed dog exposure was estimated to reduce the risk of egg, milk and nut allergies, while cat exposure was estimated to reduce the risk of egg, wheat and soybean allergies.
Dangerous plant fungus infects man in first-known global case, doctors say
Doctors diagnosed the 61-year-old man with a throat abscess caused by the same thing responsible for silver leaf disease in plants, according to a study.
Doctors diagnosed the 61-year-old man with a throat abscess caused by the same thing responsible for silver leaf disease in plants, according to a study.
Damar Hamlin pushes for AED access in Washington, D.C.
The Buffalo Bills player is teaming up with families and legislators to keep kids safe with access to automated external defibrillators (AEDs).
The Buffalo Bills player is teaming up with families and legislators to keep kids safe with access to automated external defibrillators (AEDs).
Canadian woman sets world record for donating blood: ‘I have it in me to give’
Josephine Michaluk, an 80-year-old woman from Alberta, Canada, has been donating blood for nearly six decades. Now, she’s a world record holder.
Josephine Michaluk, an 80-year-old woman from Alberta, Canada, has been donating blood for nearly six decades. Now, she’s a world record holder.
Former NBA player Eric Montross battling cancer, family says
Montross’ family issued a statement through the school on Saturday announcing the 51-year-old’s diagnosis, though it didn’t specify the nature of the cancer.
Montross’ family issued a statement through the school on Saturday announcing the 51-year-old’s diagnosis, though it didn’t specify the nature of the cancer.
Fungal infection Candida auris on the rise, appears to be resistant to most drugs
Candida auris is a fungal infection that is life-threatening -- and it's on the rise, prompting a warning from the CDC.
Candida auris is a fungal infection that is life-threatening -- and it's on the rise, prompting a warning from the CDC.
Eyedrop recall: Two more people die amid outbreak of bacteria
Three people have died from the outbreak, eight patients have suffered vision loss, and four others have had to have their eyeballs removed, according to the CDC.
Three people have died from the outbreak, eight patients have suffered vision loss, and four others have had to have their eyeballs removed, according to the CDC.
Deadly fungal infection C. auris spreading at 'alarming rate,' CDC says
The CDC called C. auris an urgent threat because it’s often resistant to antifungal drugs and spreads easily in healthcare facilities.
The CDC called C. auris an urgent threat because it’s often resistant to antifungal drugs and spreads easily in healthcare facilities.
DEA issues dire US warning of fentanyl mixed with flesh-eating 'tranq' drug
Xylazine, also known as “tranq," is a powerful animal sedative that’s known to cause open skin wounds so severe – it can lead to amputation.
Xylazine, also known as “tranq," is a powerful animal sedative that’s known to cause open skin wounds so severe – it can lead to amputation.
Biden signs bill to declassify information on COVID-19 origins
President Joe Biden has signed a bipartisan bill that directs the federal government to declassify as much intelligence as possible about the origins of COVID-19 more than three years after the start of the pandemic.
President Joe Biden has signed a bipartisan bill that directs the federal government to declassify as much intelligence as possible about the origins of COVID-19 more than three years after the start of the pandemic.